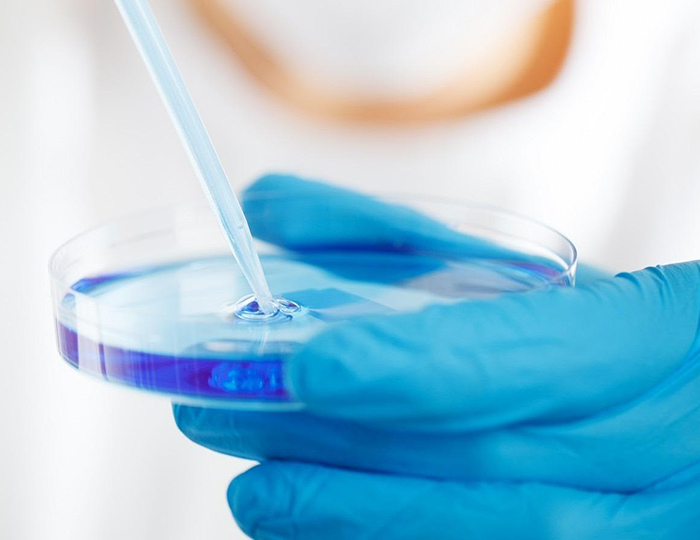
Image

hatch
hatch
技术孵化
国际学术研究与创新中心设立技术孵化版块,旨在推动优秀研究成果从理论走向实践,构建“研究—验证—转化—应用”全链条支持体系。该板块聚焦前沿科技、工程方法与数字工具等方向,通过设立孵化项目、开放实验资源、链接产业合作伙伴等方式,为具备应用潜力的研究团队提供持续支持。
中心采用“学术成果+应用前景”的遴选机制,对入库孵化项目设立专属编号与支持周期,提供阶段性资金投入、技术评估、知识产权辅导与商业化咨询等配套资源。每个项目均配有专属联络人与技术顾问团,确保其在孵化路径中可获得跨学科、跨机构的综合支持。
孵化项目成果类型包括:技术原型系统、开放工具包、实验平台、算法模型、工程工艺方案、专利产品、数字资源数据库等。部分成果由中心技术转化合作单位对接孵化器、产业联盟与基金会,推动其进入应用测试、市场试投或联合开发阶段。
中心采用“学术成果+应用前景”的遴选机制,对入库孵化项目设立专属编号与支持周期,提供阶段性资金投入、技术评估、知识产权辅导与商业化咨询等配套资源。每个项目均配有专属联络人与技术顾问团,确保其在孵化路径中可获得跨学科、跨机构的综合支持。
孵化项目成果类型包括:技术原型系统、开放工具包、实验平台、算法模型、工程工艺方案、专利产品、数字资源数据库等。部分成果由中心技术转化合作单位对接孵化器、产业联盟与基金会,推动其进入应用测试、市场试投或联合开发阶段。
hatch
当前在技术孵化项目包括:
用于中小学生的情绪识别与引导AI互动平台
项目编号:
ICARI-TI-2024-002
牵头单位:
北京师范大学心理学院、开思智能教育有限公司
研究领域:
青少年心理健康干预
状态:
完成首轮校园试点,正在拓展至市级心理热线合作体系
可嵌入式碳排放自动评估微服务接口包
项目编号:
ICARI-TI-2022-011
牵头单位:
中德低碳制造联合实验室
研究领域:
制造业碳监测与审计
状态:
通过工信部绿色工厂试点验收,转化合作协议签订中
多模态医学图像对齐算法系统原型
项目编号:
ICARI-TI-2023-005
牵头单位:
复旦大学附属华山医院、智域医学科技有限公司
研究领域:
智能影像辅助诊断
状态:
已完成二轮临床影像训练,进入院内软硬件部署阶段
* 技术孵化板块还设有“研究者开放实验申请制度”,为具备应用想法的项目团队提供共用技术资源、数据平台及模拟测试场景,并通过组织路演、技术对接日、成果开放展示周等形式推动项目社会化展示与合作扩展。所有孵化过程均在中心备案,定期接受评估与阶段验收,确保资源精准投入与成果可追溯性。


